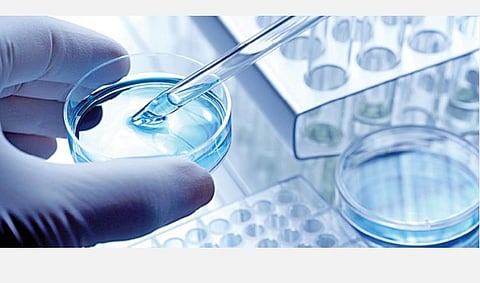
கரோனா பரிசோதனை முடிவுகளில் தவறுகள் ஏற்படுவது ஏன்?

ராஜஸ்தான், மேற்கு வங்கம் உள்ளிட்ட பல மாநிலங்களில் கரோனா வைரஸ் பரிசோதனைக்கு சீனாவில் இருந்து வாங்கப்பட்ட ‘துரிதப் பரிசோதனைப் பட்டை’கள் (Rapid Antibody Test Kits) தவறான முடிவுகளைக் காண்பித்ததால், இந்திய மருத்துவ ஆராய்ச்சிக் கழகம் அவற்றை பயன்படுத்த தடை விதித்தது. மக்கள் மத்தியில், பரிசோதனை முடிவுகள் தவறாகிப் போனால் சிகிச்சைகளும் தவறாகி விடாதா என்ற கேள்வி எழுந்துள்ளது. அதற்கான மருத்துவ அலசல் இது.
நான்கு வகை பரிசோதனைகள்:
1. துரிதப் பட்டைப் பரிசோதனை: இது, கரோனாவால் பாதிக்கப்பட்டவரின் ரத்தத்தில் நோய் எதிர் அணுக்களைப் (ஆன்டிபாடிகள்) பரிசோதிக்கிறது.அரை மணி நேரத்தில் இதன் முடிவு தெரிந்துவிடும். குறிப்பிட்ட வட்டாரத்தில் கரோனா பரவுவதாகச் சந்தேகப்பட்டால் அங்கு வசிப்பவர்கள் அனைவருக்கும் ஒரே நேரத்தில் இதை மேற்கொள்ளமுடியும். இதில் ‘பாசிட்டிவ்’ முடிவு வந்தவர்களை RT-PCR பரிசோதனைக்கு அனுப்புவார்கள்.
2. RT-PCR பரிசோதனை: கரோனா வைரஸ் பாதிப்புள்ளவர்களுக்குப் பிரதான பரிசோதனை இதுதான். பயனாளியின் சளி மாதிரியைச் சேகரித்து, RT-PCR கருவியில் கொடுத்து, அதில் கரோனா வைரஸ் மரபணு வரிசை (Genome) இருக்கிறதா என்று பரிசோதிக்கப்படுகிறது. இது கரோனா பாதிப்பை உறுதி செய்கிறது. இதற்கு சிறப்பு ஆய்வுக் கூடங்கள் தேவை. 6 மணி நேரத்தில் முடிவு தெரியும்.
3. தொகுதி RT-PCR பரிசோதனை: தொகுதி RT-PCR பரிசோதனை (Pooled RT-PCR test) என்பது RT-PCR-ல் நவீன வகை. ஒரு கரண்டி மாவால் 5 பேருக்கு தோசை வார்த்து மாவை மிச்சம் வைப்பதுபோல் ஒரு பயனாளிக்குப் பயன்படுத்தப்படும் செயல்முறையைக் கொண்டு ஒரே நேரத்தில் 5 பயனாளிகளின் சளியைப் பரிசோதித்து ‘என்சைம்’களை மிச்சம் பிடிக்கிறார்கள். இதன் முடிவு ‘நெகட்டிவ்’ என்றால், அந்த ஐந்து பேரின்முடிவும் ‘நெகட்டிவ்’தான். ஆனால், ‘பாசிட்டிவ்’ என்றால் யாருக்கு ‘பாசிட்டிவ்’ என்று தெரிந்துகொள்ள மறுபடியும் அந்த 5 பேருக்கும் RT-PCR பரிசோதனையைத் தனித்தனியாக மேற்கொள்ள வேண்டும். இந்த செயல்முறையில் வேகமாக நிறைய பேருக்கு கரோனா வைரஸ் இருப்பதை உறுதி செய்ய முடியும்.
4. ‘சிபிநாட்’ (CB-NAAT) பரிசோதனை: காச நோயாளிகளுக்கு மேற்கொள்ளப்படும் சளிப் பரிசோதனை முறை இது. இந்தக் கருவியில் சில துணைக் கருவிகளை மாற்றினால் கரோனா சளி மாதிரிகளையும் பரிசோதிக்கலாம். இது கரோனா வைரஸ் மரபணுவைப் பரிசோதிக்கிறது. இதன் முடிவு ஒரு மணி நேரத்தில் தெரிந்துவிடும்.
நான்கு வித முடிவுகள்:
கரோனாவுக்கான பரிசோதனை முடிவுகள் நான்கு விதம். 1. மெய் நெகட்டிவ் (TRUE NEGATIVE).கரோனா வைரஸ் பாதிப்பு இல்லாதவர்களுக்கு இந்த முடிவு வரும். 2. மெய் பாசிட்டிவ் (TRUEPOSITIVE). கரோனா வைரஸ் பாதிப்பு உள்ளவர்களுக்கு இந்த முடிவு. 3. பொய் நெகட்டிவ் (FALSE NEGATIVE). கரோனா வைரஸ் பாதிப்புஇருக்கும். ஆனால் முடிவு ‘இல்லை’ என்று வரும். 4. பொய் பாசிட்டிவ் (FALSE POSITIVE). கரோனா பாதிப்பு இருக்காது. ஆனால் இருப்பதாகக் காண்பிக்கும். கடைசி இரண்டும்தான் தவறானவை. கவனிக்கப்பட வேண்டியவை.
இந்தத் தவறுகள் ஏற்படுவது ஏன்?
உலகளவில் கரோனா பரிசோதனை முடிவுகளில்சுமார் 30% தவறாக இருப்பதாக ஆய்வுகள் கூறுகின்றன. அதற்கு முக்கியமான காரணங்கள் இவை: கரோனாவுக்கு இதுவரை கண்டுபிடிக்கப்பட்ட பரிசோதனைகளில் எந்தப் பரிசோதனையும் 100%துல்லியமானது இல்லை. நாவல் கரோனா வைரஸ் என்பது நான்கு மாதமே ஆன புதிய தொற்று. இதைப் பரிசோதிக்க உருவாக்கப்பட்ட கருவிகளும் முதல் தலைமுறையைச் சார்ந்தவை.
எந்தக் கருவியில் எந்த செயல்முறையில் எந்தவேதிப்பொருளில் தவறு ஏற்படுகிறது என்பதைத் தெளிவுபடுத்த இன்னும் சில காலம் ஆகலாம்.
அடுத்து, பயனாளியின் மூக்கிலும் தொண்டையிலும் சரியானஇடங்களில் சளி எடுக்கப்பட வேண்டும். சிலருக்கு கரோனா அறிவிப்புகளான இருமலோ, சளியோ இருக்காது. அப்போது அவர்களிடம் இருந்து போதுமானஅளவுக்கு சளி கிடைக்காது. மேலும், சளியை எடுப்பவருக்கு
நல்ல பயிற்சியும் தேவை. இந்தப் பிரச்சினைகளால் பரிசோதனை முடிவுகள் தவறாகிவிடக்கூடாது என்பதற்காகவே அடுத்தடுத்து இரண்டு பரிசோதனைகள் செய்கிறார்கள்.
இப்போது புதிதாக இரண்டு காரணங்களைச் சொல்கிறார்கள். ஒன்று, ஹெச்ஐவி கிருமிகளைப் போலவே நம் தடுப்பாற்றல் மண்டலத்தில் டி4 செல்எனும் ‘போலீஸ் அகடெமி’யை கரோனாவைரஸ் அழித்து விடுகிறது. அதனால் ரத்தத்தில்எதிர் அணுக்கள் எனும் ‘போலீஸ்’ இல்லாமல்போகிறது. இவர்களுக்கு கரோனா இருக்கிறது. ஆனாலும் துரிதப் பரிசோதனை முடிவுகள் ‘நெகட்டிவ்’ எனத் தவறாக காண்பிக்கும்.
மற்றொரு காரணம், கரோனா பாதிப்பு உள்ளவரிடம் கிருமிகள் உறக்க நிலையில் (Dormant) இருந்துவிட்டு, அவருக்கு எதிர்ப்பு சக்திகுறையும்போது அவை விழித்தெழுந்து நோயை உண்டாக்கலாம். கிருமிகள் உறக்க நிலையில் இருக்கும் போது கரோனா பரிசோதனைகள் அதைக் கவனிக்காமல் விட்டுவிடும். அப்போது நெகட்டிவ் என்று தவறான முடிவைக் கொடுத்துவிடும்.
சிகிச்சையில் தவறு ஏற்படாதா?
ஏற்படாது. கரோனா சிகிச்சைக்கான உத்திகள் அப்படி! மெய் நெகட்டிவ் முடிவு வந்தவர்களுக்கு எந்த சிகிச்சையும் தேவையில்லை. மெய் பாசிட்டிவ் முடிவு வந்தவர்களுக்கு பாதிப்பின் அறிகுறிகள் தெரிந்தால் கரோனா சிறப்பு வார்டுகளில் அனுமதிக்கப்பட்டு தேவையான சிகிச்சை தருகிறார்கள். சிகிச்சை முடிந்து குணமான பிறகு எடுக்கப்படும் பரிசோதனைகளில் இரண்டு முறை நெகட்டிவ் என்றுவந்தால் வீட்டுக்கு அனுப்புகிறார்கள். வீட்டிலும் 4வாரங்களுக்குத் தனிமையில் இருக்கச் சொல்கிறார்கள்.
மெய் பாசிட்டிவ் முடிவு வந்தவர்களுக்கு அறிகுறிகள் இல்லை என்றால் கரோனா வார்டுகளில் தனிமைப் படுத்தப்பட்டு 28 நாட்களுக்குக் கண்காணிக்கப்படுகிறார்கள். இரண்டு முறை நெகட்டிவ் என்று முடிவு வந்ததும் வீட்டுக்கு அனுப்புகிறார்கள். பிறகு வீட்டிலும் 2 வாரங்கள் தனிமையில் இருக்க வேண்டும். இந்த இரு பிரிவினருடன் தொடர்பு கொண்டவர்கள் அனைவரும் 4 வாரங்களுக்கு அரசின் கண்காணிப்பு வளையத்துக்குள் இருக்கிறார்கள்.
பொய் நெகட்டிவ் முடிவு வந்தவர்களை அலட்சியப்படுத்தி விட்டால் பேராபத்து. இவர்களைத்தான் மிக முக்கியமாக கவனிக்க வேண்டும். இவர்களுக்கு வெளிநாட்டுப் பயணம் அல்லது வெளிமாநிலப் பயண வரலாறு இருந்தால், கரோனா தொற்று உள்ளவர்களோடு தொடர்பு இருந்ததுஎன்றால், கரோனா அறிகுறிகள் காணப்பட்டால் நெகட்டிவ் முடிவை கருத்தில் கொள்ளாமல் சிகிச்சையைத் தொடங்கி விடுவார்கள். அறிகுறிகள் இல்லை என்றால் 28 நாட்களுக்குக் கண்காணிப்பில் வைத்திருப்பார்கள். தொடர்பு கொண்டவர்களையும் வீட்டில் 4 வாரம் கண்காணிப்புக்குக் கொண்டு வருவார்கள்.
பொய் பாசிட்டிவ் முடிவு வந்தவர்களுக்கு கரோனா பாதிப்பு இல்லை என்றாலும் அவர்கள் பாதிப்பு உள்ளவர்களாகவே கருதப்படுவார்கள். 28 நாட்களுக்கு மருத்துவமனையில் கண்காணிப்பில் இருப்பார்கள். மறுபடியும் எடுக்கப்படும் பரிசோதனையில் 2 முறை நெகட்டிவ் என வந்ததும் வீட்டுக்கு அனுப்பப்படுவார்கள். மிகுந்த மன அழுத்தத்துக்கு ஆளாகிறவர்கள் இவர்கள்தான்.
பயனாளியின் பரிசோதனை முடிவுகளில் தவறு ஏற்பட்டாலும் மருத்துவர்கள் இந்த அடிப்படையில் சிகிச்சை நெறிமுறைகளைச் சரியாக வகுத்து கரோனாவுக்குக் கதவடைப்பு செய்கிறார்கள். ஆகவே, அச்சம் வேண்டாம்.
கட்டுரையாளர், பொதுநல மருத்துவர்,
தொடர்புக்கு: gganesan95@gmail.com